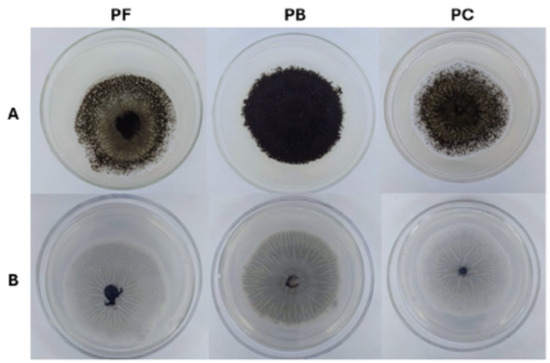
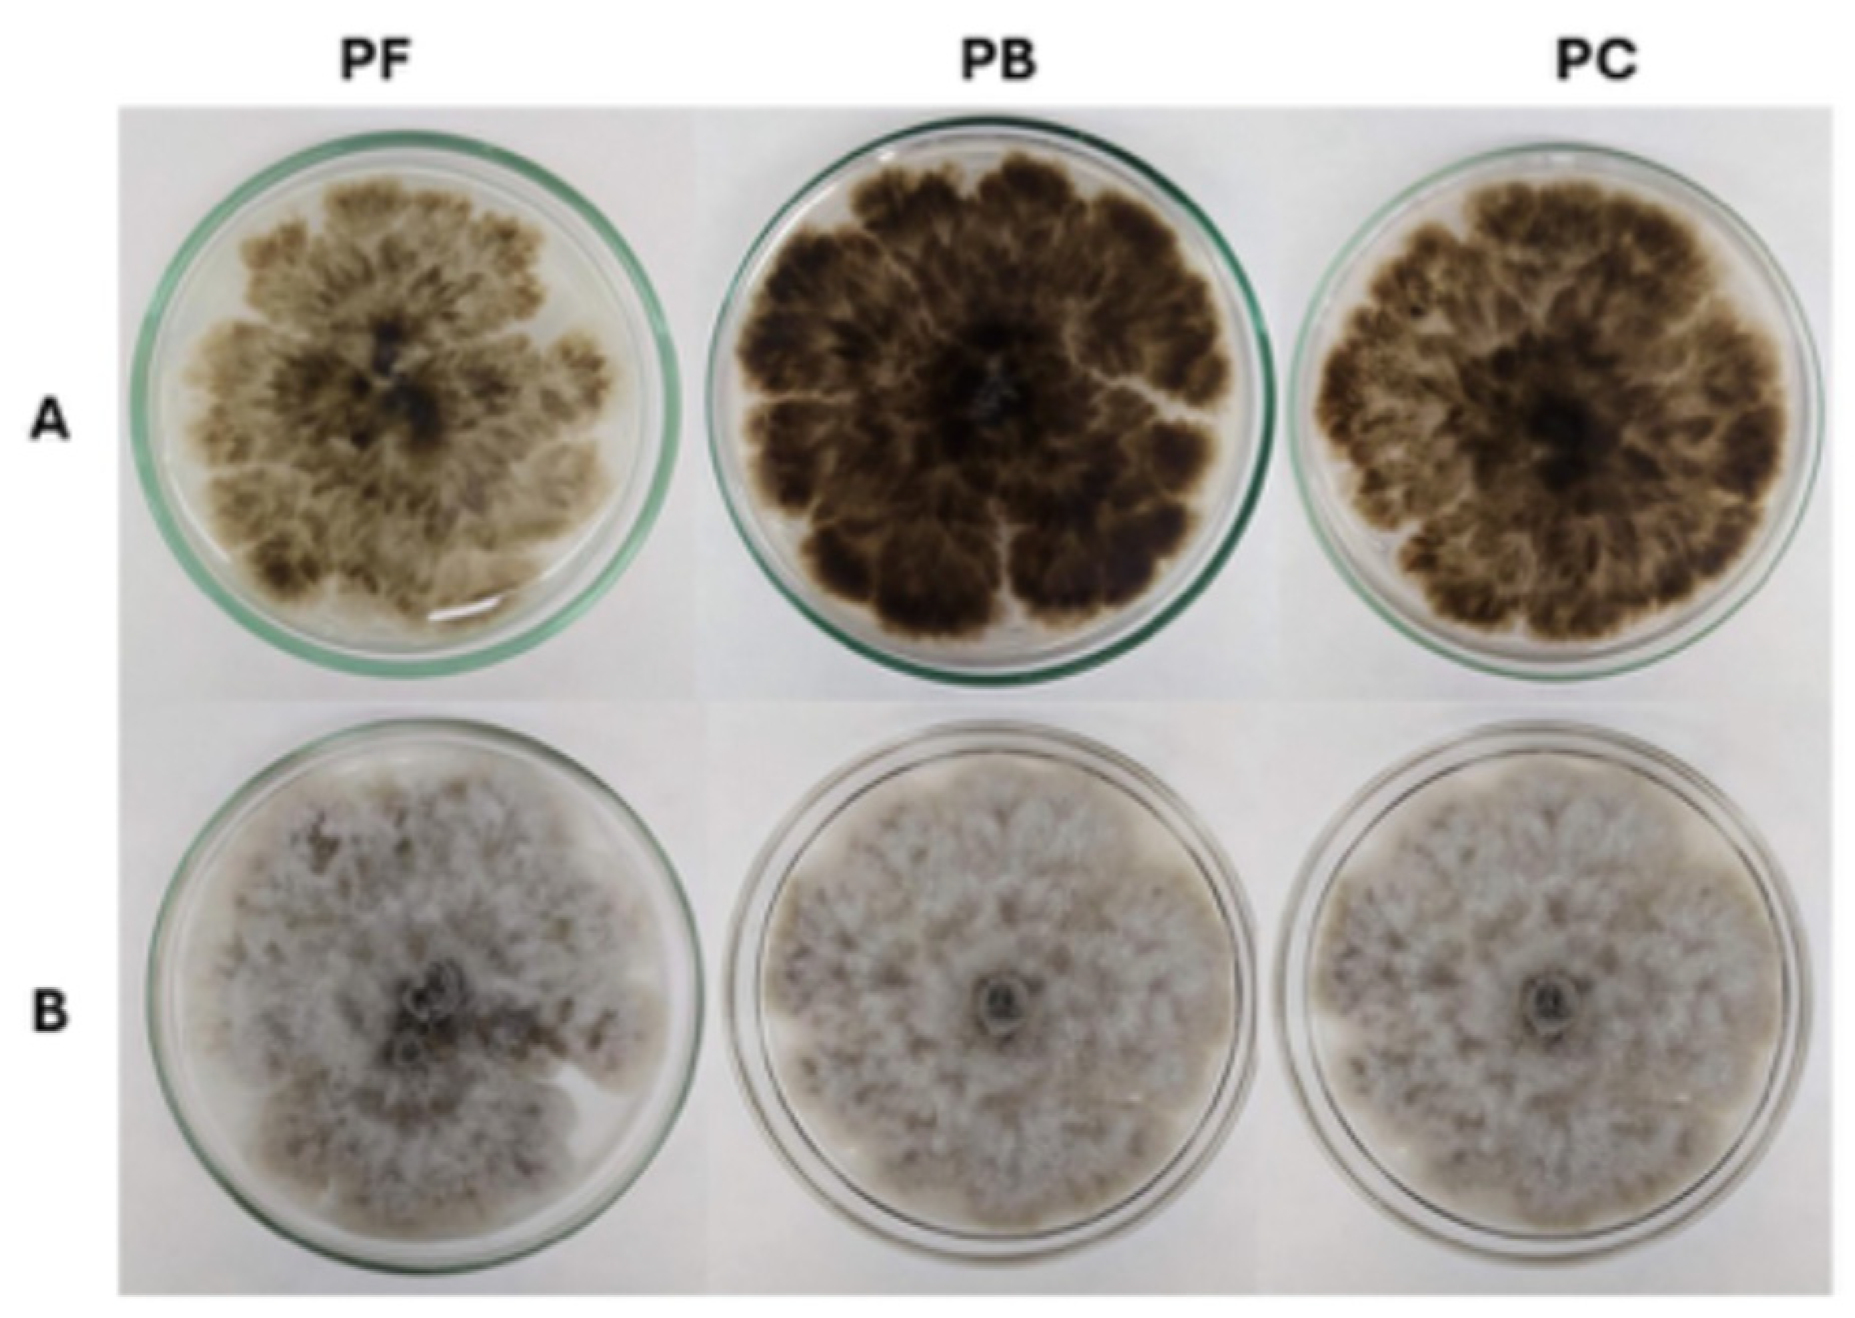
Processes 13 03834 g001
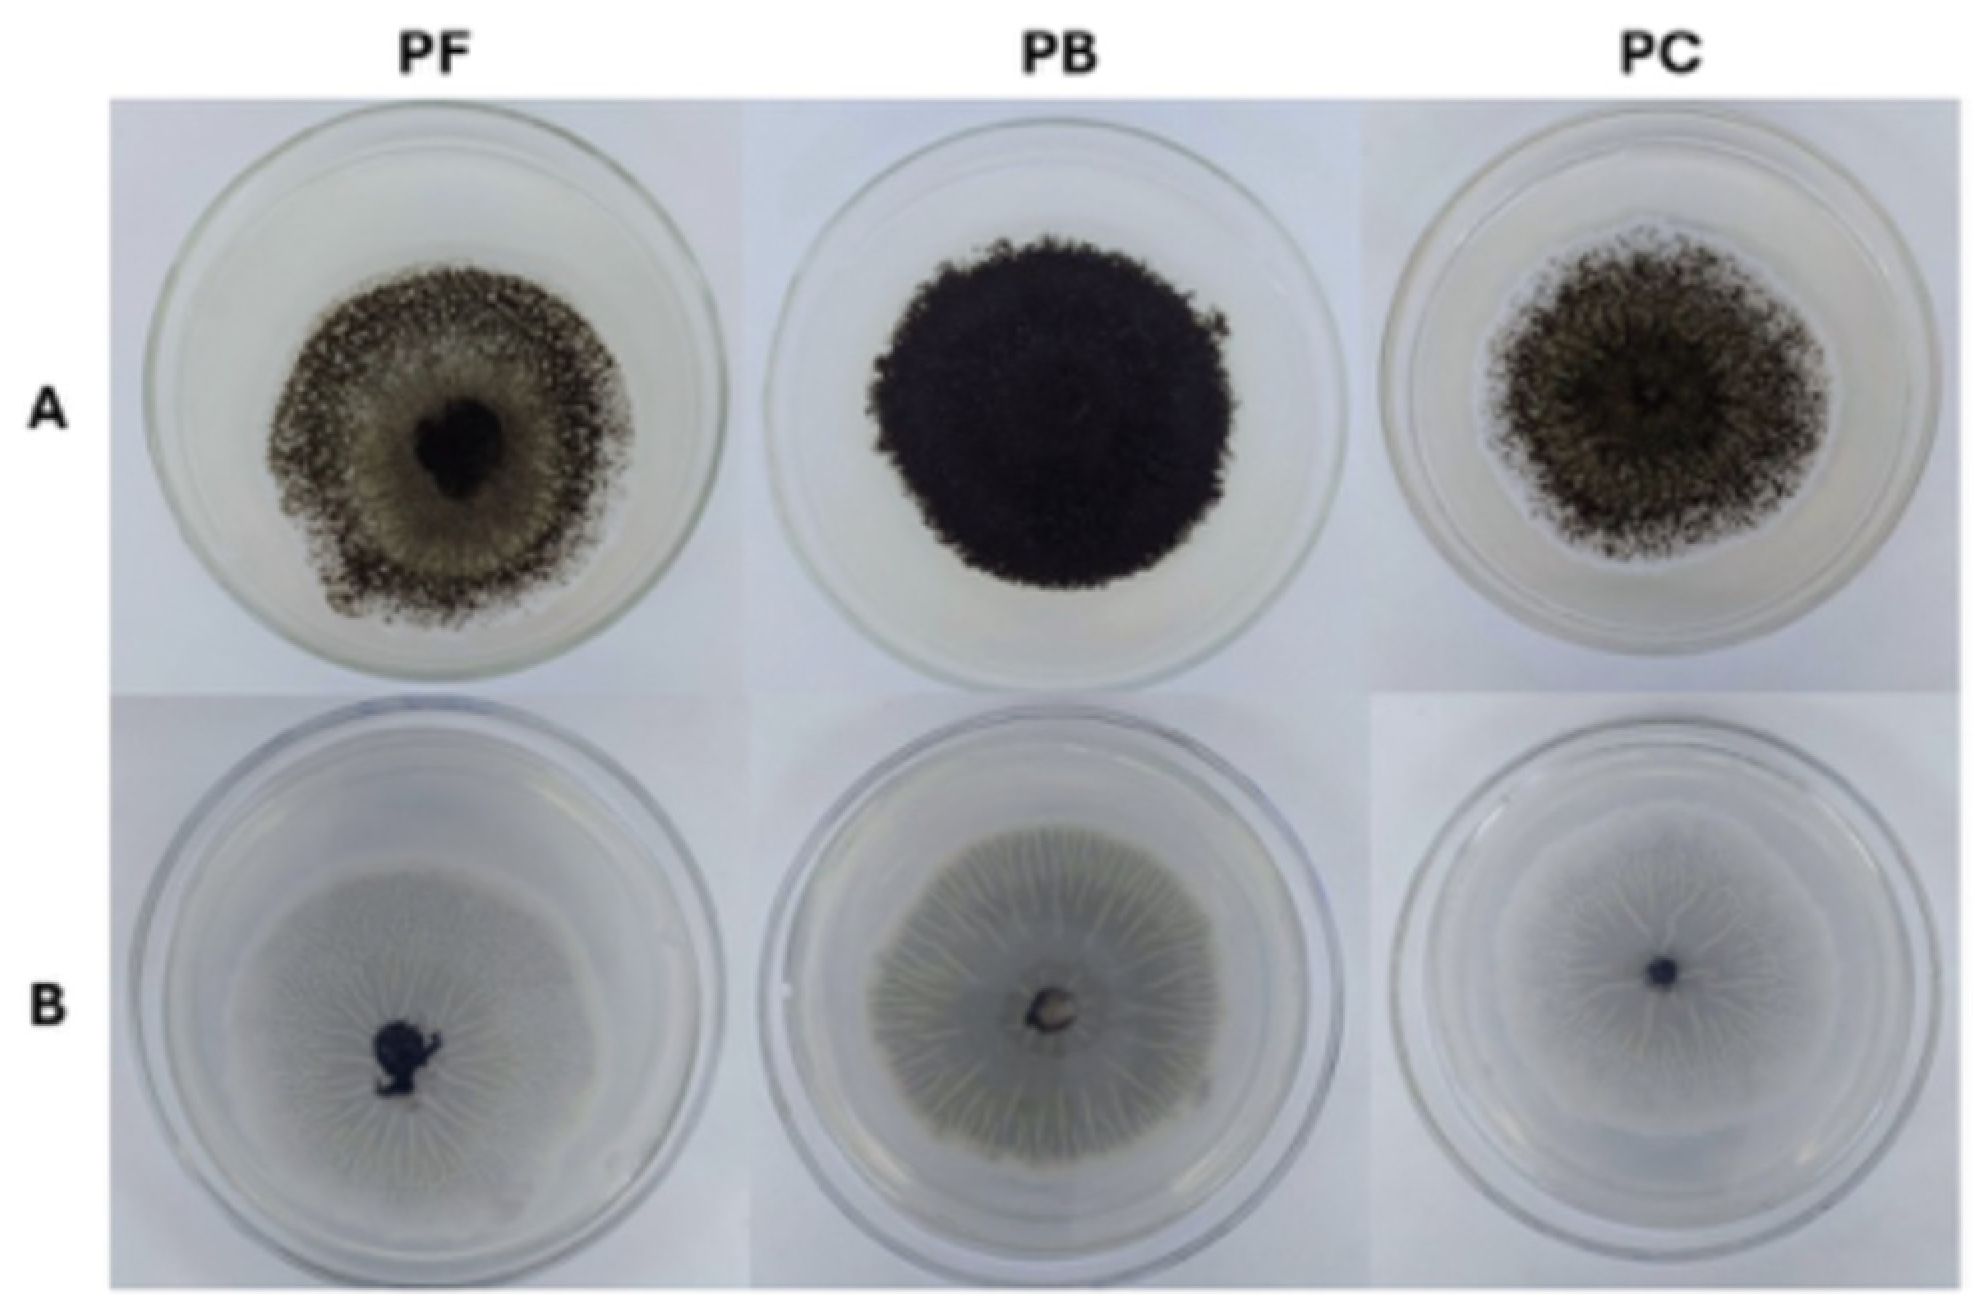
Processes 13 03834 g002

Abstract
Endophytic fungi are recognized for their capacity to produce bioactive metabolites, yet their metabolic output is strongly modulated by preservation strategies. This study evaluated the influence of three long-term preservation methods—PDA slants with mineral oil (PB), Castellani’s method (PC), and filter paper with mineral oil (PF)—on the production of phenolic compounds and antioxidant activity by the Amazonian endophytes Cophinforma mamane and Aspergillus niger. Post-reactivation morphological analyses revealed method-dependent changes in colony pigmentation, texture, and sporulation intensity. PB preservation induced the most vigorous growth and enhanced sporulation in A. niger. For extracellular metabolites (AcOEt extracts), PB yielded the highest total phenolic content in A. niger (258.24 mg GAE/g), whereas PF and PC favored C. mamane (154.48 and 153.33 mg GAE/g). For intracellular ethanolic extracts, PB was most effective for C. mamane, producing 206.19 mg GAE/g for total phenols and the highest antioxidant activities (EC50 = 1.40 mg/mL and FRAP = 95.61 µmol TE/g). HPLC–DAD identified protocatechuic acid as the predominant compound, which was especially abundant in PC and PF-preserved A. niger (60.76 and 85.38 µg/mg, respectively). Multivariate correlations indicated syringic (r = 0.53) and p-coumaric (r = 0.63) acids as the main contributors to antioxidant potential. These findings demonstrate that preservation methods may positively or negatively modulate fungal biosynthetic capacity, underscoring the importance of species-specific preservation protocols for maintaining metabolic stability in culture collections.
1. Introduction
Endophytic fungi colonize plant tissues without causing disease symptoms or morphological alterations and can be isolated from various plant organs, including leaves, stems, branches, and roots [1]. The interactions between endophytes and their host plants are complex, and evidence suggests that such symbioses can stimulate the production of secondary metabolites by the host, including alkaloids, phenolic compounds, and terpenoids [2,3,4]. This biosynthetic capacity has attracted considerable interest, as endophytic fungi are emerging as sustainable alternatives for production of plant-derived metabolites, thereby reducing pressure on endangered plant species and enabling scalable biotechnological applications [5,6,7].
The Amazon biome is a prime reservoir of microbial diversity, globally recognized for its extraordinary biodiversity and rich flora, which have long been used by local communities for medicinal purposes [8,9]. Plant species from this region host a vast community of endophytic fungi. Among these, specific isolates such as Aspergillus niger (from Myrcia guianensis) and Cophinforma mamane (from Fridericia chica) have shown particular promise, exhibiting significant antioxidant, antimicrobial, and cytotoxic potential attributed to the presence of bioactive molecules, especially phenolic compounds [7,10,11,12,13,14].
Phenolic compounds are a class of metabolites particularly noteworthy for their antioxidant properties, which are determined by the number and position of hydroxyl groups bound to the aromatic ring [15]. These molecules neutralize free radicals, thereby mitigating oxidative damage [16]. In addition to their antioxidant capacity, phenolics display anti-inflammatory activity and contribute to the prevention of chronic diseases. Within plants, they also act as signaling molecules and modulators of defense mechanisms [17,18,19].
A critical aspect in the study and utilization of these fungal biofactories is their preservation, which is essential to ensure long-term viability and the retention of biosynthetic capacity [20,21,22]. Preservation techniques must maintain not only fungal viability but also morphological, physiological, and genetic stability. The three methods tested in this study were selected for their distinct principles and widespread use: PDA slants with mineral oil (PB), a standard subculturing method valued for its simplicity and low cost [23]; Castellani’s method (PC), which employs sterile distilled water to limit metabolic activity [24]; and preservation on filter paper with mineral oil (PF) [25,26]. While PB and PF rely on mineral oil to create an anoxic barrier, PC uses water immersion. These different approaches may exert unique physiological stresses on fungi that could significantly alter their secondary metabolism. These preservation methods are commonly employed for fungi of agricultural, medicinal, and biotechnological relevance [27,28].
Despite the widespread use of culture preservation methods, there is little knowledge about how long-term storage under different conditions affects the morphological stability and metabolic performance of endophytic fungi, especially those isolated from biodiverse tropical environments of the Amazon region. Understanding these effects is essential, since preservation-induced metabolic alterations can compromise the reproducibility of secondary metabolite production and the reliability of microbial collections that support biotechnological innovation. Given this gap, this study was undertaken to evaluate how distinct preservation methods influence the morphology and production of phenolic compounds in the Amazonian endophytes Cophinforma mamane and Aspergillus niger, aiming to identify strategies that maintain their biosynthetic potential over time.
2. Materials and Methods
2.1. Reagents and Chemicals
The materials used in this study included culture media, solvents, and analytical-grade reagents. Potato Dextrose Agar (PDA) was purchased from Kasvi (São José dos Pinhais, Brazil), and yeast extract was supplied by Himedia (Thane, India). Sodium chloride (≥99.0%, analytical grade) was obtained from Synth (São Paulo, Brazil). Methanol (≥99.8%, analytical grade), ethanol (EtOH, ≥99.5%), dimethyl sulfoxide (DMSO, ≥99.9%), and ethyl acetate (AcOEt, ≥99.8%, analytical grade) were acquired from Honeywell|Riedel-de Haën (Seelze, Germany). Dextrose (≥99.5%), iron (III) chloride (≥97%), and Folin–Ciocalteu reagent were obtained from Dinâmica (Indaiatuba, Brazil). Whatman® cellulose qualitative filter paper (grade 1) was purchased from Sigma-Aldrich (St. Louis, MO, USA).
Acetonitrile (HPLC grade) was purchased from J.T. Baker (Philadelphia, PA, USA), and formic acid (HPLC grade) from LGC Biotecnologia (Cotia, Brazil). Chloroform (HPLC grade), 2,2-diphenyl-1-picrylhydrazyl (DPPH, ≥98%), 2,4,6-tripyridyl-s-triazine (TPTZ, ≥98%), Trolox (97%), gallic acid (≥99%), caffeic acid (≥98%), quinic acid (100%), chlorogenic acid (≥95%), protocatechuic acid (≥97%), resorcinol (≥99%), catechin (≥98%), 4-hydroxybenzoic acid (99%), vanillin (99%), syringic acid (≥95%), p-coumaric acid (≥98%), chicoric acid (≥95%), schaftoside (≥95.0%), taxifolin (≥90%), 3,5-dimethoxy-4-hydroxycinnamic acid (97%), salicylic acid (≥99%), rutin (≥94%), and rosmarinic acid (≥98%) were all obtained from Sigma-Aldrich (St. Louis, MO, USA).
2.2. Endophytic Fungi
The endophytic fungus Cophinforma mamane was previously isolated from the leaves of the Amazonian species Fridericia chica by De Melo Pereira et al. [11] and has been preserved in the Central Microbiological Collection of the Amazonas State University (CCM/UEA, located in Manaus, Amazonas, Brazil), under the code CCM-UEA-F0869 since 2019. The endophytic fungus Aspergillus niger was previously isolated from the leaves of Myrcia guianensis by Banhos et al. [10] and has been preserved at CCM-UEA under the code CCM-UEA-F0437 since 2011.
Both fungal strains were maintained according to the preservation protocols established by the Central Microbiological Collection (CCM/UEA), which include three methods: the Castellani method (PC), filter paper discs with mineral oil (PF), and PDA slants with mineral oil (PB). The abbreviations correspond to PC = Castellani preservation method, PF = filter paper with mineral oil, and PB = PDA slants with mineral oil.
In the Castellani method (PC) [24], mycelial fragments (5 × 5 mm) are aseptically transferred into sterile glass flasks containing 6 mL of autoclaved distilled water and sealed with rubber stoppers. This water-based preservation maintains viability by limiting nutrient availability and slowing metabolic activity. For PDA slants with mineral oil (PB) [29], the fungal strains are cultivated on sterile PDA slants and incubated at 28 °C for seven days. After confirming the purity of the culture, sterile mineral oil is gently added to fully cover the agar surface, forming a protective barrier that reduces desiccation and oxygen exposure during long-term storage. In the filter paper disc method (PF) [30], sterile discs moistened with potato dextrose broth are inoculated and incubated in Petri dishes at 28 °C for seven days. Once visible mycelial growth develops, the discs are transferred to 1.5 mL microtubes, overlaid with sterile mineral oil, and stored in labeled drawers within the collection. This technique allows rapid reactivation and easy handling of preserved isolates.
Both C. mamane and A. niger were reactivated by transferring a fragment of the stock culture to Petri dishes containing PDA, followed by incubation in a microbiological growth chamber (BOD) at 28 °C for 5 to 7 days. After the incubation period, the macroscopic morphology of the colonies (including obverse and reverse color, texture, topography, margin, and sporulation) was visually characterized and photographed for comparative analysis.
2.3. Production of Fungal Metabolites
For each preservation method and fungal species, three independent biological replicates were established. Three fungal mycelial fragments (5 × 5 mm) removed from PDA plates were inoculated into 250 mL Erlenmeyer flasks containing 150 mL of potato dextrose broth (PDB), supplemented with 0.2% yeast extract and 0.5% NaCl, adjusted to pH 5.0. Cultures were incubated under static conditions at 30 °C for 14 days, following the methodology of Gurgel et al. [7].
Metabolite extraction from the fermented broth was performed using ethyl acetate in a 1:1 ratio (broth: solvent). The mixture was agitated in an orbital shaker (KS-15, Edmund Bühler GmbH, Bodelshausen, Germany) at 120 rpm and 28 °C for 4 h, according to the method described by Gurgel et al. [7], and the ethyl acetate phase was concentrated using a rotary evaporator. The mycelium was subsequently extracted three times with 150 mL of ethanol. After vacuum filtration, the ethanolic extract was concentrated under reduced pressure using a rotary evaporator, based on the methodology described by Banhos et al. [10]. Both extracts were stored at −18 °C until further analysis.
2.4. Total Phenolic Compounds (TPC)
Phenolic compounds were quantified using the Folin–Ciocalteu method [31], employing extracts diluted at a 1:10 ratio (w/v) in ethanol. The assay was performed by mixing 0.25 mL of the extract solution with 2.75 mL of 3% Folin–Ciocalteu reagent and 0.25 mL of 10% sodium carbonate. The mixture was vortexed and incubated for 60 min at room temperature (25 °C), protected from light. Absorbance was then measured at 765 nm using a UV-Vis spectrophotometer (UV-1800, Shimadzu, Kyoto, Japan). A calibration curve prepared with gallic acid was used to quantify total phenolic content. Results were expressed as milligrams of gallic acid equivalents per gram of extract (mg GAE/g). All analyses were performed in triplicate.
2.5. Antioxidants Assays
The antioxidant potential was assessed using the 2,2-diphenyl-1-picrylhydrazyl (DPPH•) radical scavenging assay, as originally described by Brand-Williams et al. [32]. The DPPH• solution was prepared at a concentration of 0.06 mmol/L in methanol on the same day of the assay and protected from direct light. The test was conducted using a microplate spectrophotometer (Spectramax® Plus 384, Molecular Devices, San Jose, CA, USA), with samples diluted in methanol according to Duarte-Almeida et al. [33]. After 25 min of incubation in the dark, absorbance was measured at 517 nm. Ascorbic acid and quercetin were used as positive antioxidant standards. The percentage of DPPH• radical scavenging was calculated based on the difference in absorbance between the sample (Abssample) and control (Abscontrol). The effective concentration required to scavenge 50% of DPPH• radicals (EC50) was determined by linear regression using Statistica™ version 14.0.1.8 software (TIBCO, Palo Alto, CA, USA).
Antioxidant activity was also evaluated using the ferric reducing antioxidant power (FRAP) assay, as described by Benzie and Strain [34], with modifications. The FRAP reagent was composed of 100 mL of acetate buffer (0.3 mM), 10 mL of TPTZ solution (10 mM), and 10 mL of ferric chloride solution (20 mM). For the assay, 2.45 mL of FRAP reagent was incubated with 0.35 mL of each extract sample at 37 °C for 30 min, protected from light. Absorbance was measured at 595 nm using a UV-Vis spectrophotometer (UV-1800, Shimadzu, Kyoto, Japan). Extract samples were tested at 10 mg/mL. A standard calibration curve was prepared using Trolox in 10% DMSO. Results were expressed as micromoles of Trolox equivalents per gram of extract (μmol TE/g). Ascorbic acid was used as a positive control at a concentration of 40 μg/mL, and 10% DMSO was used as the blank. All analyses were performed in triplicate.
2.6. HPLC Analysis of Phenolic Compounds
Phenolic compounds were analyzed following the methodology described by Whelan et al. [35], with modifications. The analyses were performed using a UHPLC system (Nexera XR, Shimadzu, Kyoto, Japan) equipped with a diode array detector (DAD, SPD-M20A, Shimadzu). The mobile phase consisted of 10% acetonitrile and 90% aqueous formic acid solution (0.1%), with a flow rate of 1.0 mL/min. The stationary phase was a Spherisorb ODS2 column (80 Å, 5 μm, 4.6 mm × 150 mm; Waters, Milford, CT, USA). Samples were solubilized in the mobile phase at a concentration of 1.0 mg/mL and filtered through a 0.45 μm PVDF membrane filter. The injection volume was 10 μL. Three detection wavelengths were monitored: 254 nm, 280 nm, and 320 nm. Standard compounds were also diluted in the mobile phase to construct individual calibration curves for the quantification of the following phenolics: chlorogenic acid, caffeic acid, schaftoside, quinic acid, quercetin, gallic acid, protocatechuic acid, resorcinol, catechin, 4-hydroxybenzoic acid, syringic acid, p-coumaric acid, chicoric acid, taxifolin, 3,5-dimethoxy-4-hydroxycinnamic acid, salicylic acid, rutin, and rosmarinic acid. Fungal cultures were grown in triplicate (biological replicates), and each extract was analyzed by HPLC–DAD also in triplicate. Results are expressed as mean ± standard deviation for all assays.
2.7. Statistical Analysis
Data were subjected to analysis of variance (ANOVA) for homogeneous samples, followed by Tukey’s test to identify significant differences (p < 0.05). All statistical analyses were performed using Statistica™ 14.0.1.8 software (TIBCO, Palo Alto, CA, USA). Correlations between individual phenolic compounds, antioxidant activity (DPPH and FRAP), and total phenolic content were assessed using Pearson’s correlation coefficient (p < 0.05) using the same statistical software.
Principal component analysis (PCA) was also used to analyze the data and study the relationships between the two endophilic fungi species in three different preservation methods and the production of secondary metabolites (phenolic composition and antioxidant activity). All analyses were performed using SPSS software version 29.0 (SPSS IBM, Chicago, IL, USA).
3. Results
3.1. Morphological Features of Reactivated Fungi
Reactivation of C. mamane CCM-UEA-F0869 on PDA was successful for all preservation methods tested: filter paper discs in sterile mineral oil (PF), PDA slants covered with sterile mineral oil (PB), and Castellani’s method (PC), with evident fungal growth observed in all cases (Figure 1). However, the notable morphological variation observed among the preservation methods was the coloration on the reverse side of the colonies, which was intensified according to the mycelial vigor of the culture (Figure 1A). Colonies derived from PB preservation exhibited a distinct dark gray pigmentation, which was slightly less pronounced in PC-preserved cultures and significantly diminished in those reactivated from PF. Despite these differences, no variation was observed in colony texture (cottony), topography (flat) or margin (irregular), which remained consistent across all treatments.

Figure 1.
Endophytic fungus C. mamane CCM-UEA-F0869 after 7 days of growth on potato dextrose agar (PDA), derived from fungi preserved using filter paper discs in sterile mineral oil (PF), slanted PDA covered with sterile mineral oil (PB), and Castellani’s method (PC). (A) Colony obverse; (B) Colony reverse.
On the obverse side of the colonies (Figure 1B), additional differences were apparent. Colonies preserved using PC displayed a homogeneous and well-developed mycelial network, with moderate pigmentation and dense aerial hyphae. In contrast, colonies from PB preservation exhibited darker central pigmentation and more irregular distribution of mycelium. The PF-derived colonies, although viable, appeared visibly lighter and more translucent. Their color pattern was initially whitish but gradually developed a grayish tone over time, which is common in most species of this genus.
Similarly, A. niger CCM-UEA-F0437 was reactivated successfully under all preservation methods (Figure 2). As observed with C. mamane, the preservation technique had a notable impact on the morphological characteristics of the fungus. Colonies derived from PB preservation exhibited darker intracellular pigmentation and a distinctly powdery texture, indicative of increased sporulation and more mycelial vigor. On the obverse side (Figure 2A), PB-derived colonies also displayed a rougher surface and a faint grayish tint, in contrast to colonies from PC and PF preservation, which exhibited less intense pigmentation and a more homogeneous texture.
Figure 2.
Endophytic fungus A. niger CCM-UEA-F0437 after 7 days of growth on potato dextrose agar (PDA), derived from fungi preserved using filter paper discs in sterile mineral oil (PF), slanted PDA covered with sterile mineral oil (PB), and Castellani’s method (PC). (A) Colony obverse; (B) colony reverse.
On the reverse side (Figure 2B), PB-preserved cultures displayed intense central darkening, contrasting with the lighter, evenly distributed pigmentation of PC colonies and the intermediate, translucent appearance of PF. Radial striations were visible across all preservation methods but appeared sharper in PC and PF, indicating more uniform hyphal growth, configuring rugged topography in all colonies. Overall, PB preservation seemed to promote more vigorous colonies, powdery texture, and enhanced sporulation—while PC and PF better preserved structural stability and uniform growth.
3.2. Total Phenolic Content (TPC)
The total phenolic content (TPC) showed significant variation depending on the fungal species, preservation method, and extraction solvent (Table 1).

Table 1.
Total phenolic content of ethyl acetate (AcOEt) and ethanol (EtOH) extracts from endophytic fungi C. mamane CCM-UEA-F0869 and A. niger CCM-UEA-F0437 was preserved using three different methods (PF, PB, PC).
For C. mamane CCM-UEA-F0869, ethyl acetate (AcOEt) extracts from PF- and PC-preserved cultures exhibited the highest and statistically comparable TPC values (154.48 and 153.33 mg GAE/g, respectively; p < 0.05), while PB-preserved cultures yielded a significantly lower content (86.14 mg GAE/g). In contrast, for ethanolic (EtOH) extracts, PB preservation resulted in the highest TPC (206.19 mg GAE/g), markedly surpassing the significantly lower and statistically similar values observed for PF and PC (32.65 and 34.61 mg GAE/g, respectively).
In A. niger CCM-UEA-F0437, the AcOEt extracts from PB- and PC-preserved cultures consistently showed the highest TPC levels (258.24 and 254.68 mg GAE/g, respectively), significantly exceeding those obtained from PF. For EtOH extracts, TPC values were overall more moderate and less variable, with PF (48.29 mg GAE/g), followed by PC (54.73 mg GAE/g) and PB (39.55 mg GAE/g).
When comparing the two fungal species, A. niger exhibited significantly higher TPC values in AcOEt extracts across PB and PC preservation methods, suggesting a greater capacity for extracellular phenolic production under these conditions. However, under PF preservation, C. mamane showed higher TPC in the AcOEt extract, indicating a stronger response under this specific condition.
Interestingly, the opposite trend was observed for the EtOH extracts, which primarily represent intracellular phenolics (e.g., those stored within the mycelium, such as resorcinol and gallic acid [36,37]). Here, C. mamane outperformed A. niger under PB preservation (206.19 vs. 39.55 mg GAE/g), suggesting a species-specific enhancement in intracellular phenolic biosynthesis. These contrasting patterns highlight not only the influence of preservation and extraction methods but also the metabolic plasticity of each fungal strain. Such findings reinforce the importance of tailoring preservation strategies to the biological characteristics of the species and the target metabolite class (intra- vs. extracellular).
3.3. Antioxidant Activity
3.3.1. DPPH Radical Scavenging Assay
The antioxidant activity (AA%) of fungal extracts at a concentration of 10 mg/mL was evaluated using the DPPH radical scavenging assay (Table 2).

Table 2.
Antioxidant activity of ethyl acetate (AcOEt) and ethanol (EtOH) extracts from C. mamane CCM-UEA-F0869 and A. niger CCM-UEA-F0437 preserved using three different methods (PF, PB and PC), evaluated by DPPH radical scavenging assay.
The ethyl acetate extracts of C. mamane CCM-UEA-F0869 exhibited high antioxidant activity, with statistically comparable values for the PF and PC preservation methods (84.66% and 84.52%, respectively), while the PB extract showed a slightly lower AA% (80.99%). In contrast, among the ethanol extracts, PB preservation resulted in the highest AA% (82.08%), followed by PC (77.73%), with PF yielding the lowest value (54.31%).
For A. niger CCM-UEA-F0437, AcOEt extracts showed the highest AA% under the PF method (87.07%), whereas PB-preserved cultures produced the lowest activity (41.89%), with PC presenting intermediate values (61.58%). In EtOH extracts, PB and PC resulted in similarly high AA% (70.40% and 69.04%, respectively), both significantly higher than the PF-derived extract (58.52%).
Analysis of EC50 values revealed further distinctions. In C. mamane, both AcOEt and EtOH extracts preserved under PB showed the lowest EC50 values (2.80 mg/mL and 1.40 mg/mL, respectively), indicating the highest antioxidant efficiency. For A. niger, the AcOEt extract had the greatest antioxidant efficiency under PF preservation (EC50 = 2.87 mg/mL), while the PB method resulted in the poorest performance (EC50 = 13.56 mg/mL). For the EtOH extracts, PB and PC showed similarly lower EC50 values (6.48 mg/mL and 6.91 mg/mL, respectively) than PF (7.98 mg/mL), consistent with the AA% data.
Overall, C. mamane demonstrated higher antioxidant efficiency in ethanol extracts preserved with PB (EC50 = 1.40 mg/mL), suggesting enhanced intracellular metabolite accumulation under this method. In contrast, A. niger exhibited stronger extracellular antioxidant activity in AcOEt extracts under PF preservation (EC50 = 2.87 mg/mL), pointing to differential metabolic responses between species and extract types. These findings emphasize that the antioxidant potential of endophytic fungi is not only species-dependent but also highly sensitive to preservation and extraction strategies, with each condition favoring the biosynthesis or retention of specific antioxidant compounds.
3.3.2. Ferric Reducing Antioxidant Power (FRAP) Assay
In the FRAP assay, notable differences were observed in the antioxidant capacity of the evaluated extracts. For C. mamane CCM-UEA-F0869, AcOEt extracts from PF and PC preservation methods showed similar antioxidant capacity (90.20 and 89.06 µmol TE/g, respectively), whereas PB resulted in significantly lower value (72.85 µmol TE/g). In contrast, the EtOH extract exhibited reduced antioxidant power under PF (19.95 µmol TE/g), followed by a moderate increase with PC (46.47 µmol TE/g); notably, PB yielded the highest value for this fungus (95.61 µmol TE/g), surpassing even its own AcOEt extracts.
In A. niger CCM-UEA-F0437, antioxidant capacity was generally lower compared to C. mamane. The AcOEt extracts showed moderate activity levels, with PC producing the highest value (48.28 µmol TE/g), significantly greater than PF (25.17 µmol TE/g) and PC (24.51 µmol TE/g). Conversely, the EtOH extracts displayed the lowest antioxidant power across all comparisons, with PF being the preservation method associated with the weakest response (5.56 µmol TE/g). A comprehensive summary of the FRAP assay results is presented in Table 3.

Table 3.
Antioxidant activity of ethyl acetate (AcOEt) and ethanol (EtOH) extracts from C. mamane CCM-UEA-F0869 and A. niger CCM-UEA-F0437 preserved using three different methods (PF, PB, PC), evaluated by the FRAP method.
These results further highlight the species-dependent nature of antioxidant potential and the strong influence of extraction solvent and preservation method. While C. mamane responded better to PB preservation when extracted with ethanol—showing the highest FRAP value (95.61 µmol TE/g)—A. niger demonstrated superior antioxidant performance in AcOEt extracts preserved using PC (48.28 µmol TE/g).
Additionally, in both species, EtOH extracts exhibited greater sensitivity to the preservation protocol. While the absolute values for AcOEt extracts also varied, the relative performance ranking of the preservation methods (e.g., PC and PF yielding higher TPC in C. mamane, PB being superior for A. niger) was more conserved across replicates and assays for these extracellular metabolites. This suggests that the biosynthesis and stability of antioxidant compounds are differently regulated in each fungal species, and that extracellular metabolites (preferentially extracted with AcOEt) may be more resilient to preservation-induced metabolic shifts than intracellular ones (typically extracted with EtOH).
3.4. HPLC Analysis of Individual Phenolic Compounds
The phenolic compound profile, quantified by HPLC, revealed clear differences between fungal species and extract types. The main findings are summarized in Table 4.

Table 4.
Individual phenolic compounds quantified by HPLC (µg/mg) in ethyl acetate (AcOEt) and ethanol (EtOH) extracts of the endophytic fungi C. mamane CCM-UEA-F0869 and A. niger CCM-UEA-F0437 preserved using three different methods (PF, PB and PC).
Protocatechuic acid (PA) was the predominant and most frequently detected compound, present in nearly all samples. Its concentration was particularly high in the AcOEt extracts of A. niger. For instance, in the PB-preserved culture, the concentration of PA (52.72 µg/mg) was an order of magnitude higher (approximately 12 times) than the next most abundant individual phenolic, salicylic acid (4.40 µg/mg), confirming its role as the overwhelmingly dominant metabolite.
In addition to abundant PA, other compounds such as salicylic acid (SA) were identified in the AcOEt extract from PB preservation, while resorcinol (RES) was detected in the EtOH extracts.
In C. mamane, the AcOEt extracts displayed a more diverse phenolic profile, with the presence of PA, 4-hydroxybenzoic acid (HBA), syringic acid (SyA), and p-coumaric acid (p-CA). In contrast, the EtOH extracts exhibited a simpler composition, primarily dominated by PA and RES in the PF-preserved samples. In PB-preserved cultures, only trace amounts of gallic acid (GA) were detected.
3.5. Correlation Analysis and Principal Component Analysis
A correlation analysis was performed to evaluate the relationship between the antioxidant assays (DPPH and FRAP), the total phenolic compounds (TPC), and the identified phenolics, to identify which specific phenolic compounds may be contributing to the observed antioxidant responses. This integrative approach provides a more mechanistic interpretation of the data by linking chemical composition to biological activity (Table 5).

Table 5.
Pearson correlation coefficients between antioxidant activities (DPPH, FRAP), total phenolic content (TPC), and individual phenolic compounds identified in ethyl acetate and ethanol extracts from the endophytic fungi C. mamane CCM-UEA-F0869 and A. niger CCM-UEA-F0437.
The analysis revealed which compounds are potentially responsible for the measured antioxidant capacity. Notably, syringic acid and p-coumaric acid exhibited significant positive correlations with DPPH (SyA: r = 0.43; p-CA: r = 0.49) and even stronger associations with FRAP (SyA: r = 0.53; p-CA: r = 0.63). In contrast, resorcinol displayed a moderate but significant negative correlation with both FRAP (r = −0.53) and TPC (r = −0.47). Interestingly, salicylic acid exhibited a strong and significant negative correlation with DPPH (r = −0.59) but a significant positive correlation with TPC (r = 0.51).
To integrate information regarding phenolic compounds and antioxidant activity, a Principal Component Analysis (PCA) was carried out to obtain a reduced number of linear combinations of the variables that explain the greater variability in the data. The corresponding loading plots that established the relative importance of each variable are shown in Figure 3. This multivariate approach revealed global patterns and key associations among variables, explaining 68.3% of the total variance. The projections of the analyzed variables in the principal components (PCs) are the weighted sum of the original variables (Figure 3A). The first principal component (PC 1, 44.0% of the variance) was strongly correlated with several individual phenolic compounds (GA, HBA, SyA and p-CA) and antioxidant capacity (DPPH and FRAP methods). However, it was negatively correlated with RES. The second principal component (PC 2, 24.3% of the variance) was positively correlated with TPC and two individual phenolic compounds (PA and SA).

Figure 3.
Principal Component Analysis (PCA) biplot of antioxidant activities and phenolic compounds in fungal extracts. (A)—Projection of initial variables. Abbreviations: DPPH (radical scavenging activity); FRAP (ferric reducing antioxidant power); TPC (total phenolic content); GA (gallic acid); PA (protocatechuic acid); RES (resorcinol); HBA (4-hydroxybenzoic acid); SyA (syringic acid); p-CA (p-coumaric acid); SA (salicylic acid). (B)—Projection of fungi samples. Designations: Endophytic fungi: Cm (C. mamane CCM-UEA-F0869); An (A. niger CCM-UEA-F0437). Extraction solvents: AcOEt (ethyl acetate); EtOH (ethanol). Preservation methods: PF (filter paper discs in sterile mineral oil); PB (PDA slants covered with sterile mineral oil); PC (Castellani’s method).
After a cluster analysis, three different groups were formed (Figure 3B). One group was formed by the C. mamane ethyl acetate extracts, regardless of the preservation method. These samples were positioned on the positive side of the PC1 axis, characterized by higher 4 different phenolic compounds (HBA, GA, SyA and p-CA) and antioxidant capacity (DPPH and FRAP). Another group comprised the A. niger fungus ethyl acetate solvents, regardless of preservation method, and were located on the positive side of the PC2 axis. The samples were positively related to TPC and two individual phenolic compounds (PA and SA). Finally, the last group was formed by all ethanol extracts, regardless of the fungal species and the preservation method. These samples were positioned on the negative side of the PC1 axis and were positively related to Resorcinol (RES). In addition, the influence of the preservation medium on the type of individual phenolic compounds evaluated, as well as the antioxidant activity, was not observed.
4. Discussion
4.1. Fungal Morphology Preserved Under Different Media
A primary goal of microbial culture collections is to preserve fungal strains in a viable state over the long term while maintaining their original genetic, physiological, and morphological characteristics. This ensures their value for future applications in research, education, and biotechnology. For filamentous fungi, routine subculturing from aged to fresh media remains one of the most common preservation techniques [23], as adopted by CCM/UEA.
In this study, both C. mamane CCM-UEA-F0869 and A. niger CCM-UEA-F0437 were successfully reactivated from all three preservation methods tested (PF, PB, and PC), confirming their viability under long-term storage. This aligns with previous findings by Al-Bedak et al. [38], who reported high fungal survival using methods, such as periodic subculturing and mineral oil storage. However, despite successful reactivation, a systematic qualitative assessment revealed clear morphological differences among preservation treatments—particularly in pigmentation intensity on the reverse side of colonies and sporulation patterns on the obverse. These variations underscore that preservation not only affects viability but may also induce physiological stress or metabolic shifts that alter phenotypic traits. Therefore, choosing an appropriate preservation method must consider not only the ability to maintain viability but also the morphological and metabolic stability of each fungal strain.
For C. mamane, the Castellani method (PC) best preserved morphological integrity, evidenced by characteristic gray pigmentation and cottony texture (Figure 1B), in agreement with Gurgel et al. [7], who first described its morphology. Similarly, in A. niger, PC maintained key features such as the cottony-to-velvety texture transition and development of aerial mycelium (Figure 2B), consistent with the description of Gurgel [14]. These results suggest that the PC method offers a favorable microenvironment, limiting air exposure and reducing dehydration and oxidative stress through the physical barrier created by the storage medium [24,39]. Maintaining internal humidity is crucial to prevent premature sporulation and desiccation. In addition, a pigmentation gradient was noted between preservation methods in both fungi: darker gray in PB, intermediate in PC, and lighter in PF. These differences may reflect stress responses induced by preservation conditions. Long-term storage under mineral oil has been linked to morphological alterations [40,41], potentially due to oil peroxidation under inadequate handling (e.g., UV exposure or overheating), which generates toxic free radicals [42]. Such effects have been documented in sensitive systems such as in vitro embryo cultures, where peroxidized oil impairs cell development [43]. This may account for the darker pigmentation and powdery appearance observed in PB-preserved samples, possibly indicating stress-induced sporulation [44]. Additionally, progressive desiccation may occur even under optimal conditions, reinforcing the need for periodic subculturing to preserve long-term fungal viability.
4.2. Influence of Preservation and Extraction Methods on Total Phenolic Content
Total phenolic content varied significantly depending on fungal species, preservation method, and extraction solvent (Table 1). In C. mamane CCM-UEA-F0869, the PF and PC preservation methods were more effective in maintaining TPC in AcOEt extracts, which are associated with extracellular metabolites [45,46]. In contrast, EtOH extracts showed higher TPC when preserved with PB, suggesting enhanced retention of intramycelial phenolic compounds, as previously reported [47,48,49]. These findings indicate a functional association between preservation and extraction strategies: PF and PC favor the recovery of extracellular phenolics via AcOEt, while PB is more efficient for intracellular metabolites extracted with EtOH [50]. In A. niger CCM-UEA-F0437, AcOEt extracts from PB and PC showed the highest TPC; however, with PF, the yields were markedly lower, highlighting the species’ sensitivity to preservation conditions regarding extracellular metabolite production. In divergence, EtOH extracts showed smaller TPC variation across methods, with PF showing only a 37% increase over PB, while AcOEt extracts varied by up to 81%, suggesting more stable intramycelial phenolic production.
These contrasting patterns underscore the importance of aligning preservation and extraction methods to the metabolic characteristics of each fungal strain. The results also reinforce the need for future studies to explicitly report preservation strategies, as they may directly influence secondary metabolite profiles.
4.3. Impact of Preservation Conditions on Intra- and Extracellular Antioxidant Metabolites
The antioxidant activity of the fungal extracts was influenced by species, extraction solvent, and preservation methods. In the DPPH assays (Table 2), the endophytic fungus C. mamane CCM-UEA-F0869 consistently exhibited high radical scavenging activity (AA > 80%) in ethyl acetate extracts (extracellular metabolites), with ethyl acetate extracts (extracellular metabolites) consistently showing high PB preservation, yielding the greatest efficiency (lowest EC50). In contrast, ethanol extracts (intracellular metabolites) varied more: while PF and PC showed moderate activity, PB led to the highest AA% (82.08%) and the lowest EC50 (1.40 mg/mL), suggesting that preservation influences intracellular antioxidant metabolite retention.
Furthermore, the high antioxidant activity in PB-preserved EtOH extracts, despite a less diverse phenolic profile, suggests the presence of non-phenolic antioxidants. We hypothesize that PB preservation may induce the accumulation of intracellular, non-polar metabolites such as sesquiterpenes or fatty acids [51,52]. Ethanol, due to its polarity and ability to disrupt cell membranes, is particularly effective at extracting such intracellular components from the mycelium compared to ethyl acetate, which is more selective for metabolites already secreted into the culture broth.
In the case of A. niger CCM-UEA-F0437, AcOEt extracts from PF had the highest antioxidant activity (EC50 = 2.87 mg/mL), while PB resulted in the lowest antioxidant performance. EtOH extracts showed less variation, though PF again yielded the weakest antioxidant activity. These findings emphasize that preservation methods can differentially affect intra- and extracellular metabolites.
When comparing with previous studies, our C. mamane PC/AcOEt extracts showed lower antioxidant capacity than reported by Gurgel et al. [7], possibly due to differences in medium composition (e.g., yeast extract concentration), inoculum vigor, or long-term subculturing effects—supporting the hypothesis of strain degeneration over time [53].
The PB method was particularly ineffective for preserving antioxidant activity in A. niger AcOEt extracts, despite maintaining high TPC. This discrepancy may appear from enzymatic degradation of secreted metabolites in solid cultures under oil, while intracellular compounds remain more protected. In contrast, PC and PF may better inhibit enzymatic activity, preserving both intra- and extracellular fractions [42,43].
The FRAP assay supported these patterns (Table 3). For C. mamane, AcOEt extracts had consistently high reducing power under PF and PC, while PB again favored EtOH extracts, mirroring TPC data. In A. niger, AcOEt extracts showed moderate FRAP values (higher in PC), whereas EtOH extracts had overall lower antioxidant activity, particularly under PF.
Comparative analysis with literature data [12,13] suggests a decline in biosynthetic output, likely due to cumulative subculturing. The marked impact of preservation and extraction strategies, especially in A. niger, highlights their relevance—on par with medium and culture conditions—in shaping metabolite profiles. These findings support the use of optimization frameworks like OSMAC [54,55] to enhance bioactive compound yields.
4.4. Influence of Preservation Conditions on Fungal Phenolic Diversity
HPLC analysis (Table 4) revealed that both the diversity and concentration of phenolic compounds were strongly influenced by fungal species, extraction solvent, and preservation method. In C. mamane CCM-UEA-F0869, protocatechuic acid was the predominant metabolite, consistently detected across most extracts—suggesting metabolic stability under varying conditions. Protocatechuic acid is well documented to exhibit several bioactivities, including antioxidant, anti-inflammatory, neuroprotective, and anticancer [56,57]. Notably, protocatechuic acid was absent in the PB-preserved EtOH extract. In A. niger CCM-UEA-F0437, PA was also the main phenolic, particularly abundant in AcOEt extracts, with concentrations exceeding those in C. mamane. This reinforces the role of protocatechuic acid as a key metabolite in this fungal species. In A. niger, PA was also absent from one preservation method (PC) when extracted with ethanol. The fact that the only extracts that did not present PA were ethanol extracts, combined with the fact that all extracts with higher concentrations of PA were extracted with ethyl acetate, reinforces the higher efficacy of this methodology to extract protocatechuic acid.
An important observation was the discrepancy between total phenolic content and HPLC-quantified compounds—especially in PB/EtOH extracts of C. mamane, where high TPC values contrasted with low individual phenolic detection. This may reflect the presence of phenolics not included among the HPLC standards, or of non-phenolic reducing agents (e.g., sesquiterpenes or fatty acids) [51]. In contrast, A. niger AcOEt extracts showed strong agreement between TPC and HPLC data obtained. The lack of correlation between the main detected phenolic compound (protocatechuic acid) and TPC values is evidence that there are non-detected phenolics present in the extract. These phenolics could be detected in future studies with the use of more advanced detection methods, such as mass spectroscopy.
Chemical diversity was greater in AcOEt than in EtOH extracts. PB preservation yielded unique profiles in both fungi, including the exclusive detection of salicylic acid in A. niger and the highest compound diversity in C. mamane. This suggests that the physiological stress imposed by the PB method—likely anoxia and resource limitation under mineral oil—actively shifts metabolic flux within the shikimate acid pathway. The shikimate pathway is a well-known hub for specialized metabolism in fungi, capable of generating a wide array of phenolic compounds, lipids, and pigments through its core intermediates and branch points [58]. Specifically, the synthesis of salicylic acid points to a preferential activation of the biosynthetic branch leading to this specific stress-responsive compound, possibly at the expense of other branches producing metabolites like protocatechuic acid, which was absent in the corresponding EtOH extract. The overall increase in diversity in C. mamane further implies that PB stress triggers a broader, non-specific deregulation of its secondary metabolome, a common adaptive response in fungi facing suboptimal conditions.
Finally, the absence of compounds like caffeic acid—previously reported in C. mamane and linked to its antioxidant action [13]—may indicate loss of metabolic capacity due to strain degeneration [53], reinforcing the value of cryopreservation methods for maintaining biosynthetic potential in biotechnologically relevant fungi [59]. Overall, these results show that preservation methods not only impact metabolite yield but also shape chemical composition, directly influencing extract functionality and potential applications. A preliminary analysis of the relationship between the chemical profiles and bioactivities revealed a notable disconnect: while protocatechuic acid was the most abundant phenolic across most extracts, its presence did not directly correlate with the observed antioxidant potency. Instead, specific compounds like syringic acid and p-coumaric acid appeared to be stronger drivers of antioxidant activity, a relationship that is statistically validated in the following chemometric analysis.
4.5. Chemometric Insights into Antioxidant Drivers and Metabolite Correlations
The correlation analysis revealed a significant positive relationship between total phenolic content (TPC) and FRAP values, while TPC showed little to no correlation with DPPH. This aligns with previous findings that link FRAP—based on single electron transfer (SET)—more directly with the reducing power of phenolic compounds [60,61]. In contrast, DPPH, which operates via mixed HAT/SET mechanisms, can respond to a broader spectrum of antioxidant metabolites, including non-phenolic compounds [62]. Thus, while FRAP better captures phenolic-driven activity, DPPH likely reflects both phenolic and non-phenolic contributions.
A key finding that emerges from this analysis is the apparent disconnect between metabolite abundance and antioxidant efficacy. Protocatechuic acid (PA), despite being the most frequently detected and abundant phenolic compound, showed a neutral correlation with both DPPH and FRAP assays. This observation provides a critical insight: chemical abundance is not a direct proxy for bioactivity.
The explanation lies in the structure–activity relationships of phenolic compounds. Among the individual phenolics, syringic acid and p-coumaric acid showed strong positive correlations with both FRAP and DPPH, highlighting their role as the major antioxidant contributors. Their chemical structures—bearing methoxy and hydroxyl groups in specific arrangements—enable efficient radical stabilization and electron donation [63,64]. In contrast, the specific dihydroxy structure of protocatechuic acid, while contributing to TPC, may possess a less favorable redox potential for the specific reactions underpinning these antioxidant assays compared to the more potent syringic and p-coumaric acids.
Principal component analysis (PCA) visually confirmed this functional divergence. Syringic and p-coumaric acids clustered tightly with DPPH and FRAP, reinforcing their central role in the antioxidant response. In contrast, protocatechuic acid and TPC formed a distinct group, isolated from the main antioxidant clusters. This pattern indicates that while PA is a dominant component of the metabolic profile, it does not account for most of the observed antioxidant performance in this system, underscoring that high concentration alone does not guarantee high activity, particularly if other potent contributors are present or if synergistic effects are absent [65,66,67].
Conversely, resorcinol showed a negative correlation with TPC and FRAP, suggesting a distinct biosynthetic origin via the polyketide pathway [68], in contrast to shikimic acid-derived compounds like protocatechuic acid or p-coumaric acid [69]. Its presence may indicate a reallocation of cellular resources under specific conditions. Preservation stress, particularly from the PB method, likely forces the fungus to prioritize rapid energy production and membrane integrity [70]. In this scenario, the polyketide pathway yielding resorcinol might be favored as a more direct or less energy-demanding response compared to the multi-step shikimate pathway for antioxidant phenolics [68], effectively shifting the metabolic output towards stress survival compounds over specialized antioxidants.
Similarly, salicylic acid (SA) showed limited correlation with antioxidant activity, likely due to its indirect mechanism of action (e.g., signaling functions rather than direct radical scavenging) [71,72]. Thus, this acid showed a significant positive correlation with TPC (r = 0.51) but a strong negative correlation with DPPH (r = −0.59). This contrast highlights that SA is not a primary driver of the observed radical scavenging activity. Its role is likely more aligned with signaling functions, and its accumulation may indicate a metabolic state distinct from the one that maximizes the production of potent antioxidants like syringic and p-coumaric acids. In addition, this metabolic state may be associated with the production of other non-detected phenolic compounds that may even be present in high concentrations, therefore contributing to creating a correlation between SA and TPC, even if SA itself is not present in high concentrations.
Beyond identifying key antioxidant drivers, our results invite speculation on the underlying metabolic interactions shaped by preservation. The strong positive correlation of syringic acid (SyA) and p-coumaric acid (p-CA) with antioxidant activity, contrasted with the neutral role of the abundant protocatechuic acid (PA)—a key intermediate in the shikimate pathway—suggests a potential metabolic branching point. Preservation stress may differentially regulate specific downstream steps within the phenylpropanoid pathway.
For instance, the PB method’s anoxic stress in C. mamane might not suppress the early shikimate pathway (hence high PA) but could upregulate later steps such as methylation and hydroxylation, favoring the production of SyA and p-CA. These latter compounds possess superior antioxidant potency due to their methoxy and propenyl groups that enhance radical stabilization [63,64]. Furthermore, the negative correlation of resorcinol with phenolic-driven activity hints at a competitive metabolic relationship.
While resorcinol can be synthesized via polyketide synthase (PKS) systems, its accumulation under certain preservation conditions may indicate a shift in cellular resources or a stress response that diverts precursors away from the shikimate pathway or its antioxidant-rich phenylpropanoid branches. Although our study confirms preservation-induced metabolic reprogramming, future work using transcriptomics is needed to validate the regulation of these specific pathway branches and to elucidate any synergistic or antagonistic relationships between the compounds identified. Furthermore, to directly deconvolute the contribution of the identified phenolics to the overall antioxidant activity, future pharmacological studies should measure the antioxidant capacity of pure syringic acid, p-coumaric acid, and protocatechuic acid standards, both individually and in combination. This would allow for the experimental confirmation of their relative potency and the identification of any synergistic or antagonistic interactions that may influence the bioactivity of the complex fungal extracts.
Together, these results reinforce a crucial conclusion: antioxidant activity is better explained by the presence of specific and potent phenolics—especially syringic and p-coumaric acids—than by the total phenolic load or the prevalence of any single, abundant metabolite. This clarifies why a predominant compound like PA can exhibit neutral correlations, as its metabolic role or chemical mechanism may be distinct from driving the primary antioxidant responses measured here.
4.6. Limitations and Practical Applications
While this study provides compelling evidence for the influence of preservation methods on fungal metabolomes, some limitations should be acknowledged. The HPLC analysis, although informative, was restricted to a specific set of phenolic standards. The application of untargeted metabolomic approaches (e.g., LC-MS) would enable a more comprehensive understanding of the metabolic shifts induced by different preservation methods. Moreover, the exact molecular mechanisms underlying the observed metabolic reprogramming remain hypothetical and should be further validated through transcriptomic or enzymatic activity analyses.
Despite these limitations, our findings hold important practical implications. For culture collections and biotechnology laboratories, this work offers clear and specific guidelines. Although the conclusions are limited to the fungal species studied, additional research across other genera is necessary to determine which preservation methods maximize the production of extracellular or intracellular phenolic compounds, depending on the aims of each investigation. This study demonstrates that a simple and cost-effective modification of the preservation protocol can substantially enhance the recovery of valuable metabolites without altering cultivation conditions. By tailoring preservation strategies to the fungal species and the target metabolite class (intracellular or extracellular), researchers can more reliably conserve and exploit the biosynthetic potential of fungal collections for drug discovery, biotechnology, and other industrial applications.
5. Conclusions
This study systematically demonstrates that preservation method, fungal species, and extraction solvent are critical, interdependent factors shaping the metabolic profile and antioxidant activity of endophytic fungi. Key findings reveal that no single preservation method is universally optimal. The PB method enhanced radical scavenging (DPPH) in C. mamane, while the PC method better preserved morphological integrity and improved ferric reducing (FRAP) capacity. Furthermore, we identified syringic acid and p-coumaric acid as key antioxidants, underscoring that total phenolic content is a poor predictor of activity, especially when measured using the DPPH method.
Critically, our research fills a gap in the literature by suggesting that preservation strategies do more than maintain viability—they actively modulate fungal metabolism, potentially suppressing specific bioactive metabolites. This insight is crucial for microbial culture collections and research on natural products, as it positions the preservation protocol not as a mere storage step, but as a key variable for optimizing the recovery of functional metabolites.
The main practical application of this work is providing clear, actionable guidelines for culture collection management and bioprospecting. Thus, we suggest employing PB preservation to target intracellular antioxidants from C. mamane, while using PC preservation to maintain morphological integrity and stable extracellular metabolite profiles. Furthermore, we advocate adopting a strategy of ‘metabolite-targeted preservation’—maintaining strains via multiple methods—to maximize the diversity and reliability of the metabolomic inventory.
While this study provides a robust framework, its limitations—focusing on two species and phenolic antioxidants—define the path for future research. Expanding this approach to a broader range of fungal taxa, preservation systems, and target metabolite classes (e.g., antimicrobials, anticancer agents) is essential to build predictive models that fully harness fungal metabolic plasticity. Ultimately, by strategically selecting and diversifying preservation protocols, we can maximize the biotechnological yield from fungal resources, accelerating their application in pharmacology and agriculture.
Author Contributions
Conceptualization, Y.P.-A., L.d.S.F. and P.M.A.; methodology, L.K.B., P.M.A. and S.D.J.; software, A.C.C. and L.d.S.F.; validation, L.d.S.F., A.M.J. and P.M.A.; formal analysis, L.d.S.F., P.M.A. and A.M.J.; investigation, Y.P.-A., A.T.F.d.S., C.P.d.A. and P.V.M.d.S.; resources, P.M.A. and S.D.J.; data curation, Y.P.-A., L.d.S.F. and A.C.C.; writing—original draft preparation, Y.P.-A.; writing—review and editing, L.d.S.F., A.M.J., L.K.B. and P.M.A.; supervision, P.M.A. and L.d.S.F.; project administration, P.M.A.; funding acquisition, P.M.A. and S.D.J. All authors have read and agreed to the published version of the manuscript.
Funding
This research was funded by Fundação de Amparo à Pesquisa do Estado do Amazonas (FAPEAM) (grant numbers 01.02.016301.00568/2021-05 and 01.02.016301.00101/2024-08) and by Coordenação de Aperfeiçoamento de Pessoal de Nível Superior (CAPES) (finance code 001 and grant number 88887.909577/2023-00—PRAPG).
Data Availability Statement
The original contributions presented in this study are included in the article; further inquiries can be directed to the corresponding authors.
Acknowledgments
The authors gratefully acknowledge Universidade do Estado do Amazonas—UEA, FAPEAM and CAPES for supporting this research.
Conflicts of Interest
The authors declare no conflicts of interest.
Abbreviations
The following abbreviations are used in this manuscript:
| PC | Castellani preservation method |
| PF | Filter paper with mineral oil |
| PB | PDA slants with mineral oil |
| AcOEt | Ethyl acetate |
| EtOH | Ethanol |
| DMSO | Dimethyl sulfoxide |
| PDA | Potato dextrose agar |
| PDB | Potato dextrose broth |
| DPPH | 2,2-Diphenyl-1-picrylhydrazyl |
| FRAP | Ferric reducing antioxidant power |
| EC50 | Effective concentration |
| AA | Antioxidant activity |
| TPTZ | 2,4,6-Tripyridyl-s-triazine |
| TPC | Total phenolic content |
| GAE | Gallic acid equivalent |
| TE | Trolox equivalent |
| GA | Gallic acid |
| PA | Protocatechuic acid |
| RES | Resorcinol |
| HBA | 4-Hydroxybenzoic acid |
| SyA | Syringic acid |
| p-CA | p-Coumaric acid |
| SA | Salicylic acid |
| PCA | Principal components analysis |
| CCM | Microbiological Collections Center |
| SET | Single electron transfer |
| HAT | Hydrogen atom transfer |
References
- Mengistu, A.A. Endophytes: Colonization, Behavior, and Their Role in Defense Mechanism. Int. J. Microbiol. 2020, 2020, 6927219. [Google Scholar] [CrossRef] [PubMed]
- Jha, P.; Kaur, T.; Chhabra, I.; Panja, A.; Paul, S.; Kumar, V.; Malik, T. Endophytic Fungi: Hidden Treasure Chest of Antimicrobial Metabolites Interrelationship of Endophytes and Metabolites. Front. Microbiol. 2023, 14, 1227830. [Google Scholar] [CrossRef] [PubMed]
- Galindo-Solís, J.M.; Fernández, F.J. Endophytic Fungal Terpenoids: Natural Role and Bioactivities. Microorganisms 2022, 10, 339. [Google Scholar] [CrossRef] [PubMed]
- Tiwari, P.; Bae, H. Endophytic Fungi: Key Insights, Emerging Prospects, and Challenges in Natural Product Drug Discovery. Microorganisms 2022, 10, 360. [Google Scholar] [CrossRef]
- Omomowo, I.O.; Amao, J.A.; Abubakar, A.; Ogundola, A.F.; Ezediuno, L.O.; Bamigboye, C.O. A Review on the Trends of Endophytic Fungi Bioactivities. Sci. Afr. 2023, 20, e01594. [Google Scholar] [CrossRef]
- Prajapati, C.; Rai, S.N.; Singh, A.K.; Chopade, B.A.; Singh, Y.; Singh, S.K.; Haque, S.; Prieto, M.A.; Ashraf, G.M. An Update of Fungal Endophyte Diversity and Strategies for Augmenting Therapeutic Potential of Their Potent Metabolites: Recent Advancement. Appl. Biochem. Biotechnol. 2025, 197, 2799–2866. [Google Scholar] [CrossRef]
- Gurgel, R.S.; de Melo Pereira, D.Í.; Garcia, A.V.F.; Fernandes de Souza, A.T.; Mendes da Silva, T.; de Andrade, C.P.; Lima da Silva, W.; Nunez, C.V.; Fantin, C.; de Lima Procópio, R.E.; et al. Antimicrobial and Antioxidant Activities of Endophytic Fungi Associated with Arrabidaea chica (Bignoniaceae). J. Fungi 2023, 9, 864. [Google Scholar] [CrossRef]
- Nascimento Brito, V.; Lana Alves, J.; Sírio Araújo, K.; de Souza Leite, T.; Borges de Queiroz, C.; Liparini Pereira, O.; de Queiroz, M.V. Endophytic Trichoderma Species from Rubber Trees Native to the Brazilian Amazon, Including Four New Species. Front. Microbiol. 2023, 14, 1095199. [Google Scholar] [CrossRef]
- Castro Braga, F. Brazilian Traditional Medicine: Historical Basis, Features and Potentialities for Pharmaceutical Development. J. Tradit. Chin. Med. Sci. 2021, 8, S44–S50. [Google Scholar] [CrossRef]
- dos Banhos, E.F.; de Souza, A.Q.L.; de Andrade, J.C.; de Souza, A.D.L.; Koolen, H.H.F.; Albuquerque, P.M. Endophytic Fungi from Myrcia guianensis at the Brazilian Amazon: Distribution and Bioactivity. Braz. J. Microb. 2014, 45, 153–162. [Google Scholar] [CrossRef]
- de Melo Pereira, D.Í.; Gurgel, R.S.; de Souza, A.T.F.; Matias, R.R.; de Souza Falcão, L.; Chaves, F.C.M.; da Silva, G.F.; Martínez, J.G.; de Lima Procópio, R.E.; Fantin, C.; et al. Isolation and Identification of Pigment-Producing Endophytic Fungi from the Amazonian Species Fridericia chica. J. Fungi 2024, 10, 77. [Google Scholar] [CrossRef] [PubMed]
- de Falcão, L.S.; de Oliveira, I.L.; Gurgel, R.S.; de Souza, A.T.F.; de Mendonça, L.S.; Usuda, É.O.; do Amaral, T.S.; Veggi, P.C.; Campelo, P.H.; de Vasconcellos, M.C.; et al. Development of Cassava Starch-Based Films Incorporated with Phenolic Compounds Produced by an Amazonian Fungus. Int. J. Biol. Macromol. 2024, 258, 128882. [Google Scholar] [CrossRef] [PubMed]
- Gurgel, R.S.; Pereira, D.I.M.; Martins, B.; Falcão, L.S.; Lacerda, C.D.; Neves, C.M.B.; Pinto, A.F.; Jordão, A.M.; Albuquerque, P.M. Global Phenolic Composition and Antioxidant Capacity of Extracts from the Endophytic Fungi Cophinforma mamane with Potential Use in Food Systems: The Effects of Time, Temperature, and Solvent on the Extraction Process. Appl. Sci. 2024, 14, 8784. [Google Scholar] [CrossRef]
- Gurgel, R.S.; Rodrigues, J.G.C.; Matias, R.R.; Batista, B.N.; Oliveira, R.L.; Albuquerque, P.M. Biological Activity and Production of Metabolites from Amazon Endophytic Fungi. Afr. J. Microbiol. Res. 2020, 14, 85–93. [Google Scholar] [CrossRef][Green Version]
- Kruk, J.; Aboul-Enein, B.H.; Duchnik, E.; Marchlewicz, M. Antioxidative Properties of Phenolic Compounds and Their Effect on Oxidative Stress Induced by Severe Physical Exercise. J. Physiol. Sci. 2022, 72, 19. [Google Scholar] [CrossRef]
- Chandimali, N.; Bak, S.G.; Park, E.H.; Lim, H.-J.; Won, Y.-S.; Kim, E.-K.; Park, S.-I.; Lee, S.J. Free Radicals and Their Impact on Health and Antioxidant Defenses: A Review. Cell Death Discov. 2025, 11, 19. [Google Scholar] [CrossRef]
- Liu, W.; Cui, X.; Zhong, Y.; Ma, R.; Liu, B.; Xia, Y. Phenolic Metabolites as Therapeutic in Inflammation and Neoplasms: Molecular Pathways Explaining Their Efficacy. Pharmacol. Res. 2023, 193, 106812. [Google Scholar] [CrossRef]
- Wang, W.; Du, L.; Wei, Q.; Lu, M.; Xu, D.; Li, Y. Synthesis and Health Effects of Phenolic Compounds: A Focus on Tyrosol, Hydroxytyrosol, and 3,4-Dihydroxyacetophenone. Antioxidants 2025, 14, 476. [Google Scholar] [CrossRef]
- Goura, K.; Legrifi, I.; Kallali, N.S.; Taoussi, M.; Kenfaoui, J.; Meddich, A.; Esmaeel, Q.; Ait Barka, E.; Lahlali, R. Beyond Survival: The Role of Secondary Metabolites in Plant Defense Mechanisms. J. Crop Health 2025, 77, 121. [Google Scholar] [CrossRef]
- Smith, D. Culturing, Preservation and Maintenance of Fungi. In The UK National Culture Collection (UKNCC) Biological Resource: Properties, Maintenance and Management; Smith, D., Day, J.G., Ryan, M.J., Eds.; Pineapple Planet Design Studio Ltd.: Egham, UK, 2001; pp. 384–409. [Google Scholar]
- dos Reis, J.B.A.; Lorenzi, A.S.; do Vale, H.M.M. Methods Used for the Study of Endophytic Fungi: A Review on Methodologies and Challenges, and Associated Tips. Arch. Microbiol. 2022, 204, 675. [Google Scholar] [CrossRef]
- Ayala-Zermeño, M.A.; Berlanga-Padilla, A.M.; Regla-Márquez, C.F.; Lino-López, G.J.; Muñiz-Paredes, F.; Montesinos-Matías, R.; Sánchez-González, J.A. Long-Term Preservation and Genetic Stability of Entomopathogenic Fungal Species. J. Microbiol. Methods 2023, 208, 106711. [Google Scholar] [CrossRef]
- Hu, X.; Webster, G.; Xie, L.; Yu, C.; Li, Y.; Liao, X. A New Method for the Preservation of Axenic Fungal Cultures. J. Microbiol. Methods 2014, 99, 81–83. [Google Scholar] [CrossRef]
- Castellani, A. Viability of Some Pathogenic Fungi in Distilled Water. J. Trop. Med. Hyg. 1939, 42, 225–226. [Google Scholar]
- Nakasone, K.K.; Peterson, S.W.; Jong, S.-C. Preservation And Distribution Of Fungal Cultures. In Biodiversity of Fungi; Mueller, G.M., Bills, G.F., Foster, M.S., Eds.; Elsevier: Amsterdam, The Netherlands, 2004; pp. 37–47. [Google Scholar]
- Guimarães, L.C.; Fernandes, A.P.; Chalfoun, S.M.; Batista, L.R. Methods to Preserve Potentially Toxigenic Fungi. Braz. J. Microbiol. 2014, 45, 43–47. [Google Scholar] [CrossRef][Green Version]
- Borman, A.M.; Szekely, A.; Campbell, C.K.; Johnson, E.M. Evaluation of the Viability of Pathogenic Filamentous Fungi after Prolonged Storage in Sterile Water and Review of Recent Published Studies on Storage Methods. Mycopathologia 2006, 161, 361–368. [Google Scholar] [CrossRef] [PubMed]
- Michaliski, L.F.; Ióca, L.P.; Oliveira, L.S.; Crnkovic, C.M.; Takaki, M.; Freire, V.F.; Berlinck, R.G.S. Improvement of Targeted Fungi Secondary Metabolite Production Using a Systematic Experimental Design and Chemometrics Analysis. Methods Protoc. 2023, 6, 77. [Google Scholar] [CrossRef]
- Stebbins, M.E.; Robbins, W.J. Mineral Oil and Preservation of Fungous Cultures. Mycologia 1949, 41, 632–636. [Google Scholar] [CrossRef]
- Fong, Y.K.; Anuar, S.; Lim, H.P.; Tham, F.Y.; Sanderson, F.R. A Modified Filter Paper Technique for Long-Term Preservation of Some Fungal Cultures. Mycologist 2000, 14, 127–130. [Google Scholar] [CrossRef]
- Singleton, V.L.; Rossi, J.A. Colorimetry of Total Phenolics with Phosphomolybdic-Phosphotungstic Acid Reagents. Am. J. Enol. Vitic. 1965, 16, 144–158. [Google Scholar] [CrossRef]
- Brand-Williams, W.; Cuvelier, M.E.; Berset, C. Use of a Free Radical Method to Evaluate Antioxidant Activity. LWT-Food Sci. Technol. 1995, 28, 25–30. [Google Scholar] [CrossRef]
- Duarte-Almeida, J.M.; dos Santos, R.J.; Genovese, M.I.; Lajolo, F.M. Evaluation of the antioxidant activity using the beta-carotene/linoleic acid system and the DPPH scavenging method. Food Sci. Technol. 2006, 26, 446–452. [Google Scholar] [CrossRef]
- Benzie, I.F.F.; Strain, J.J. The Ferric Reducing Ability of Plasma (FRAP) as a Measure of “Antioxidant Power”: The FRAP Assay. Anal. Biochem. 1996, 239, 70–76. [Google Scholar] [CrossRef] [PubMed]
- Whelan, L.C.; Geary, M.; Healy, J. A Novel, Simple Rapid Reverse-Phase HPLC-DAD Analysis, for the Simultaneous Determination of Phenolic Compounds and Abscisic Acid Commonly Found in Foodstuff and Beverages. J. Chromatogr. Sci. 2022, 60, 648–654. [Google Scholar] [CrossRef] [PubMed]
- Krupodorova, T.; Barshteyn, V.; Dzhagan, V.; Pluzhnyk, A.; Zaichenko, T.; Blume, Y. Enhancement of An-tioxidant Activity and Total Phenolic Content of Fomitopsis pinicola Mycelium Extract. Fungal Biol. Biotechnol. 2024, 11, 18. [Google Scholar] [CrossRef]
- Ulusu, F.; Emsen, B.; Karapinar, H.S.; Uzun, Y.; Kaya, A. HPLC Based Identification of Phenolics and Biological Activities in Elaphomyces Mushroom Extracts. Sci. Rep. 2025, 15, 27182. [Google Scholar] [CrossRef]
- Al-Bedak, O.A.; Sayed, R.M.; Hassan, S.H.A. A New Low-Cost Method for Long-Term Preservation of Filamentous Fungi. Biocatal. Agric. Biotechnol. 2019, 22, 101417. [Google Scholar] [CrossRef]
- Homolka, L. Methods of Cryopreservation in Fungi. In Laboratory Protocols in Fungal Biology; Gupta, V.K., Ed.; Springer: New York, NY, USA, 2013; pp. 9–16. [Google Scholar]
- da Silva, A.M.M.; Borba, C.M.; de Oliveira, P.C. Viability and Morphological Alterations of Paracoccidioides brasiliensis Strains Preserved under Mineral Oil for Long Periods of Time. Mycoses 1994, 37, 165–169. [Google Scholar] [CrossRef]
- Barreira, T.; Corrêa-Moreira, D.; Borba, C.; Moraes, A.; Oliveira, M. Molecular and Phenotypic Reidentification of Sporothrix schenckii Clinical Isolates Preserved under Mineral Oil for 34 to 64 Years in a Culture Collection in Brazil. Curr. Res. Microb. Sci. 2022, 3, 100128. [Google Scholar] [CrossRef]
- Aguilar, G.; Mazzamaro, G.; Rasberger, M. Oxidative Degradation and Stabilisation of Mineral Oil-Based Lubricants. In Chemistry and Technology of Lubricants; Springer: Dordrecht, The Netherlands, 2009; pp. 107–152. [Google Scholar]
- Scarica, C.; Monaco, A.; Borini, A.; Pontemezzo, E.; Bonanni, V.; De Santis, L.; Zacà, C.; Coticchio, G. Use of Mineral Oil in IVF Culture Systems: Physico-Chemical Aspects, Management, and Safety. J. Assist. Reprod. Genet. 2022, 39, 883–892. [Google Scholar] [CrossRef]
- Su, Y.-Y.; Qi, Y.-L.; Cai, L. Induction of Sporulation in Plant Pathogenic Fungi. Mycology 2012, 3, 195–200. [Google Scholar] [CrossRef]
- Singh, V.K.; Kumar, A. Secondary Metabolites from Endophytic Fungi: Production, Methods of Analysis, and Diverse Pharmaceutical Potential. Symbiosis 2023, 90, 111–125. [Google Scholar] [CrossRef] [PubMed]
- Abdel-Nasser, A.; Hathout, A.S.; Badr, A.N.; Barakat, O.S.; Fathy, H.M. Extraction and Characterization of Bioactive Secondary Metabolites from Lactic Acid Bacteria and Evaluating Their Antifungal and Antiaflatoxigenic Activity. Biotechnol. Rep. 2023, 38, e00799. [Google Scholar] [CrossRef] [PubMed]
- Gautam, V.S.; Singh, A.; Kumari, P.; Nishad, J.H.; Kumar, J.; Yadav, M.; Bharti, R.; Prajapati, P.; Kharwar, R.N. Phenolic and Flavonoid Contents and Antioxidant Activity of an Endophytic Fungus Nigrospora sphaerica (EHL2), Inhabiting the Medicinal Plant Euphorbia hirta (Dudhi) L. Arch. Microbiol. 2022, 204, 140. [Google Scholar] [CrossRef] [PubMed]
- Jamal, H.A.A.; Husaini, A.; Sing, N.N.; Roslan, H.A.; Zulkharnain, A.; Akinkunmi, W.A. Characterization of Bioactive Compounds Produced by Endophytic Fungi Isolated from Gynura procumbens (Sambung Nyawa). Braz. J. Microbiol. 2022, 53, 1857–1870. [Google Scholar] [CrossRef]
- Nouioura, G.; El Fadili, M.; El Barnossi, A.; Loukili, E.H.; Laaroussi, H.; Bouhrim, M.; Giesy, J.P.; Aboul-Soud, M.A.M.; Al-Sheikh, Y.A.; Lyoussi, B.; et al. Comprehensive Analysis of Different Solvent Extracts of Ferula communis L. Fruit Reveals Phenolic Compounds and Their Biological Properties via in Vitro and in Silico Assays. Sci. Rep. 2024, 14, 8325. [Google Scholar] [CrossRef]
- Alara, O.R.; Abdurahman, N.H.; Ukaegbu, C.I. Extraction of Phenolic Compounds: A Review. Curr. Res. Food. Sci. 2021, 4, 200–214. [Google Scholar] [CrossRef]
- Tan, C.; Liu, Z.; Chen, S.; Huang, X.; Cui, H.; Long, Y.; Lu, Y.; She, Z. Antioxidative Polyketones from the Mangrove-Derived Fungus ascomycota Sp. SK2YWS-L. Sci. Rep. 2016, 6, 36609. [Google Scholar] [CrossRef]
- Li, H.-L.; Li, X.-M.; Li, X.; Wang, C.-Y.; Liu, H.; Kassack, M.U.; Meng, L.-H.; Wang, B.-G. Antioxidant Hydroanthraquinones from the Marine Algal-Derived Endophytic Fungus Talaromyces islandicus EN-501. J. Nat. Prod. 2017, 80, 162–168. [Google Scholar] [CrossRef]
- Danner, C.; Mach, R.L.; Mach-Aigner, A.R. The Phenomenon of Strain Degeneration in Biotechnologically Relevant Fungi. Appl. Microbiol. Biotechnol. 2023, 107, 4745–4758. [Google Scholar] [CrossRef]
- Lutfia, A.; Munir, E.; Yurnaliza, Y.; Basyuni, M.; Oku, H. Chemical Profiling of Fungal Metabolites via the OSMAC Approach: Novel Identification of Brianthein W from an Endophytic Fungus, Hypomontagnella monticulosa Zg15SU. Curr. Res. Microb. Sci. 2024, 7, 100288. [Google Scholar] [CrossRef]
- de Andrade, C.P.; Lacerda, C.D.; Valente, R.A.; Rocha, L.S.d.H.; de Souza, A.T.F.; Pereira, D.Í.d.M.; Barbosa, L.K.; Fantin, C.; Duvoisin Junior, S.; Albuquerque, P.M. An OSMAC Strategy for the Production of Antimicrobial Compounds by the Amazonian Fungi Talaromyces pinophilus CCM-UEA-F0414 and Penicillium paxilli CCM-UEA-F0591. Antibiotics 2025, 14, 756. [Google Scholar] [CrossRef] [PubMed]
- Cadena-Iñiguez, J.; Santiago-Osorio, E.; Sánchez-Flores, N.; Salazar-Aguilar, S.; Soto-Hernández, R.M.; Riviello-Flores, M.d.l.L.; Macías-Zaragoza, V.M.; Aguiñiga-Sánchez, I. The Cancer-Protective Potential of Protocatechuic Acid: A Narrative Review. Molecules 2024, 29, 1439. [Google Scholar] [CrossRef] [PubMed]
- Song, J.; He, Y.; Luo, C.; Feng, B.; Ran, F.; Xu, H.; Ci, Z.; Xu, R.; Han, L.; Zhang, D. New Progress in the Pharmacology of Protocatechuic Acid: A Compound Ingested in Daily Foods and Herbs Frequently and Heavily. Pharmacol. Res. 2020, 161, 105109. [Google Scholar] [CrossRef] [PubMed]
- Shende, V.V.; Bauman, K.D.; Moore, B.S. The Shikimate Pathway: Gateway to Metabolic Diversity. Nat. Prod. Rep. 2024, 41, 604–648. [Google Scholar] [CrossRef]
- Zalesky, T.; Bradshaw, A.J.; Bair, Z.J.; Meyer, K.W.; Stamets, P. Fungal Cryopreservation across 61 Genera: Practical Application and Method Evaluation. Mycologia 2024, 116, 865–876. [Google Scholar] [CrossRef]
- Rumpf, J.; Burger, R.; Schulze, M. Statistical Evaluation of DPPH, ABTS, FRAP, and Folin-Ciocalteu Assays to Assess the Antioxidant Capacity of Lignins. Int. J. Biol. Macromol. 2023, 233, 123470. [Google Scholar] [CrossRef]
- Kiss, A.; Papp, V.A.; Pál, A.; Prokisch, J.; Mirani, S.; Toth, B.E.; Alshaal, T. Comparative Study on Antioxidant Capacity of Diverse Food Matrices: Applicability, Suitability and Inter-Correlation of Multiple Assays to Assess Polyphenol and Antioxidant Status. Antioxidants 2025, 14, 317. [Google Scholar] [CrossRef]
- Christodoulou, M.C.; Orellana Palacios, J.C.; Hesami, G.; Jafarzadeh, S.; Lorenzo, J.M.; Domínguez, R.; Moreno, A.; Hadidi, M. Spectrophotometric Methods for Measurement of Antioxidant Activity in Food and Pharmaceuticals. Antioxidants 2022, 11, 2213. [Google Scholar] [CrossRef]
- Leopoldini, M.; Russo, N.; Toscano, M. The Molecular Basis of Working Mechanism of Natural Polyphenolic Antioxidants. Food Chem. 2011, 125, 288–306. [Google Scholar] [CrossRef]
- Nieto, S.; Martinez-Mora, F.; Lozano, I.; Ruiz, F.J.; Villa, R.; Lozano, P. New Sustainable Biocatalytic Approach for Producing Lipophilic (Hydroxy)Cinnamic Esters Based on Deep Eutectic Mixtures. Catal. Today 2024, 431, 114500. [Google Scholar] [CrossRef]
- Gulcin, İ.; Alwasel, S.H. DPPH Radical Scavenging Assay. Processes 2023, 11, 2248. [Google Scholar] [CrossRef]
- Rodríguez-Bonilla, P.; Gandía-Herrero, F.; Matencio, A.; García-Carmona, F.; López-Nicolás, J.M. Comparative Study of the Antioxidant Capacity of Four Stilbenes Using ORAC, ABTS+, and FRAP Techniques. Food Anal. Methods 2017, 10, 2994–3000. [Google Scholar] [CrossRef]
- Baliyan, S.; Mukherjee, R.; Priyadarshini, A.; Vibhuti, A.; Gupta, A.; Pandey, R.P.; Chang, C.-M. Determi-nation of Antioxidants by DPPH Radical Scavenging Activity and Quantitative Phytochemical Analysis of Ficus religiosa. Molecules 2022, 27, 1326. [Google Scholar] [CrossRef] [PubMed]
- Sokolova, N.; Denisov, S.S.; Hackl, T.; Haslinger, K. Unravelling the Functional Diversity of Type III Polyketide Synthases in Fungi. Angew. Chem. Int. Ed. 2025, 64, e202514786. [Google Scholar] [CrossRef]
- Mathur, S.; Singh, D.; Ranjan, R. Production of Phenolic Secondary Metabolites by Fungal Endophytes: Importance and Implication. In Fungal Secondary Metabolites; Elsevier: Amsterdam, The Netherlands, 2024; pp. 537–556. [Google Scholar]
- Yu, W.; Pei, R.; Zhang, Y.; Tu, Y.; He, B. Light Regulation of Secondary Metabolism in Fungi. J. Biol. Eng. 2023, 17, 57. [Google Scholar] [CrossRef]
- Mirzamohammad, E.; Alirezalu, A.; Alirezalu, K.; Norozi, A.; Ansari, A. Improvement of the Antioxidant Activity, Phytochemicals, and Cannabinoid Compounds of Cannabis sativa by Salicylic Acid Elicitor. Food Sci. Nutr. 2021, 9, 6873–6881. [Google Scholar] [CrossRef]
- Hawash, M.; Jaradat, N.; Abualhasan, M.; Thaher, M.; Sawalhi, R.; Younes, N.; Shanaa, A.; Nuseirat, M.; Mousa, A. In Vitro and in Vivo Assessment of the Antioxidant Potential of Isoxazole Derivatives. Sci. Rep. 2022, 12, 18223. [Google Scholar] [CrossRef]
Disclaimer/Publisher’s Note: The statements, opinions and data contained in all publications are solely those of the individual author(s) and contributor(s) and not of MDPI and/or the editor(s). MDPI and/or the editor(s) disclaim responsibility for any injury to people or property resulting from any ideas, methods, instructions or products referred to in the content. |
© 2025 by the authors. Licensee MDPI, Basel, Switzerland. This article is an open access article distributed under the terms and conditions of the Creative Commons Attribution (CC BY) license (https://creativecommons.org/licenses/by/4.0/).